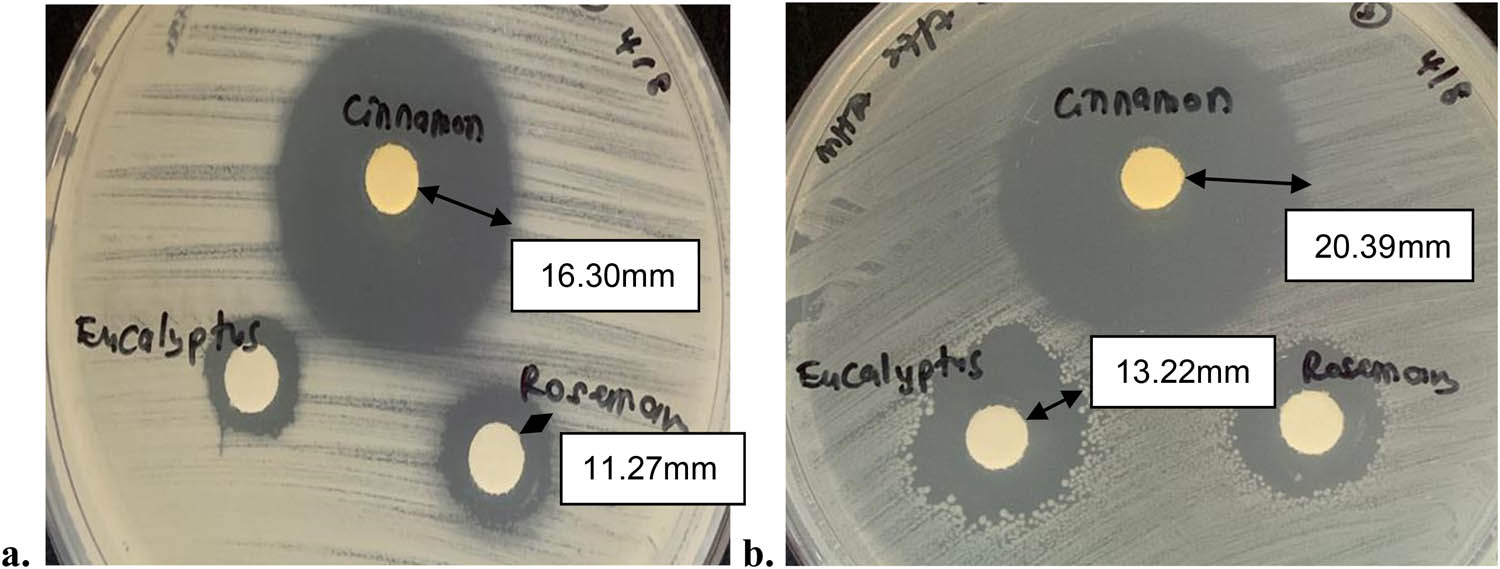

Effect of plasticizers on the properties of sugar palm nanocellulose/cinnamon essential oil reinforced starch bionanocomposite films
-
Razali Mohamad Omar Syafiq
, Salit Mohd Sapuan, Mohamed Yusoff Mohd Zuhri
, Siti Hajar Othman and Rushdan Ahmad Ilyas
Abstract
This work examines the effects of plasticizer type and concentration on mechanical, physical, and antibacterial characteristics of sugar palm nanocellulose/sugar palm starch (SPS)/cinnamon essential oil bionanocomposite films. In this research, the preparation of SPS films were conducted using glycerol (G), sorbitol (S), and their blend (GS) as plasticizers at ratios of 1.5, 3.0, and 4.5 wt%. The bionanocomposite films were developed by the solution casting method. Plasticizer Plasticizers were added to the SPS film-forming solutions to help overcome the fragile and brittle nature of the unplasticized SPS films. Increasing plasticizer contents resulted in an increase in film thickness and moisture contents. On the contrary, the increase in plasticizer concentrations resulted in the decrease of the densities of the plasticized films. The increase in the plasticizer content from 1.5 to 4.5% revealed less influence towards the moisture content of S-plasticised films. For glycerol and glycerol-sorbitol plasticized (G and GS) films, higher moisture content was observed compared to S-plasticised films. Various plasticizer types did not significantly modify the antibacterial activity of bionanocomposite films. The findings of this study showed significant improvement in the properties of bionanocomposite films with different types and concentrations of plasticizers and their potential for food packaging applications was enhanced.
Graphical abstract
Processing of bionanocomposite film with various types and concentrations of plasticizers.

1 Introduction
Petroleum-based polymers are broadly utilized in the packaging industry due to their remarkable flexibility, barrier, and mechanical capabilities [1,2,3,4,5]. Despite their various benefits, petroleum-based plastics is among the major sources of pollutions for being non-biodegradable. However, as they originate from non-renewable resources including toxic and harmful substances, they pose severe health and environmental risks [6,7,8]. Non-biodegradable polymer packaging products are very resistant to microbial attacks that stay in the environment for decades after disposal. Because of their nonbiodegradability and non-renewable sources, petroleum-based plastics are regarded as one of the leading causes of solid waste formation and deposition in the environment. The rapid petroleum reserves depletion, along with the fact that petroleum-based polymers are nonbiodegradable, has raised concerns about their widespread use in packaging. The plastic polymers advantages, e.g. clear optical, low cost, easy availability, mechanical qualities, heat sealability, and resistance to water and grease have proved them to be the most practical and cost-effective alternative for packaging applications [1,7,9,10].
Responding to this problem, various research groups and industrial organizations around the world are presently working on new eco-friendly packaging solutions that take advantage of biopolymer’s “ecological” benefits in applications such as food packaging [11]. New materials made from renewable resources have exploded in popularity during the last decade [12]. Most of the research focused on polysaccharides, proteins, and lipids to be used in edible films. The technological properties could be improved via chemical reactions (e.g. cross-linking) or physical treatments (e.g. ultrasound, heat, or radiation) to change their molecular structures [13,14]. Various studies confirmed the growing interest in the utilization of starch derived from numerous sources incorporated with essential oils (EOs) to prepare biobased packaging films. The rigidity of bionanocomposite films is contributed by the strong interactions between amylose–amylopectin or amylose–amylose in the polymer matrix [15,16,17,18]. By adding a plasticizer, these films’ inherent brittleness and rigidity are reduced, while their malleability, ductility, and flexibility are increased. In literature studies, the addition of nanofillers into a biopolymer matrix led to an improvement in the properties of biopolymer-based packaging films including enhanced mechanical, thermal, barrier, and physicochemical properties [19,20,21]. On the other hand, it is not very common to study the effect of the plasticizer type and concentration on the films of sugar palm nanocellulose reinforced sugar palm starch (SPS)/cinnamon essential oil (CEO) bionanocomposite films. Recent studies by Ilyas et al. [13], Syafiq et al. [1], and Sanyang et al. [7] have highlighted the sugar palm tree as a promising source of starch for biopolymer use. Sugar palm (Arenga pinnata), a versatile tree, is native to many tropical countries, most notably South-East Asia. The tree is well-known for its various economic applications [22,23,24]. Additionally, starch can be collected from the trunk of the tree, especially when the tree no longer produced fruits and sugar [25]. Traditionally, SPS is utilized as a feedstock for materials [26]. According to Ilyas et al. [27] and Nazrin et al. [28], SPS film containing 0.5% sugar palm nanocellulose revealed improved tensile strength of 140% [27] and water vapour permeability of 19.94% [28]. Nevertheless, it still has not gained the attention it requires to be developed as an industrial starch biopolymer. Starch is regarded among the most promising biopolymers owing to their benefits, e.g. renewability, biodegradability, low cost, and abundant availability [1,7,29,30]. Starch is also the primary source of carbohydrates in tuber and cereal plants, e.g. cassava and corn, respectively, comprising two macromolecules, which are amylose and amylopectin. It is extensively used to develop biodegradable film due to the advantages it offers, e.g. affordability, availability, and excellent film-forming ability [31,32]. The proportion of linear homopolymer amylose to highly branched amylopectin is dependent on the plant starch source and could influence their processing behaviour and final product characteristics [7].
From the packaging industry perspective, starch-based materials are gaining traction in the bio-based polymers market for a variety of packaging applications. Native starches, on the other hand, are brittle and lack thermoplastic properties. As a result, products derived from native starches crumble easily when dried in environmental conditions. The starches’ brittle nature is a result of the strong intermolecular hydrogen bonds between the macromolecular network chains of amylose and amylopectin [27,33,34]. Plasticizers combined with higher temperatures and shear improve the native starches’ flexibility to a level comparable to that of conventional thermoplastic polymers [11,35].
Antibacterial packaging is making inroads in the food industry due to its ability to inhibit microbial activity in foods during their processing and storage, consequently, lengthening their shelf life [29,36]. EOs are shown to be effective as preservatives and antibacterials in food, suggesting that they may be a viable substitute to synthetic compounds [1,37]. The majority of the antibacterial substances found in EOs are shown to be beneficial for microbial population control via targeting foodborne microorganisms, resulting in higher-quality and safer food products [38]. Syafiq et al. [1] and Mith et al. [39] determined the antibacterial performances of commercial EOs derived from cinnamon, eucalyptus, thyme, and rosemary against food-borne pathogenic bacteria and bacteria associated with food spoilage. According to the findings of the aforementioned studies, bioactive components, e.g. carvacrol, cinnamaldehyde, eugenol, and thymol, demonstrated significant antibacterial activities against all bacteria tested [39]. The EOs’ antibacterial activity is associated with the presence of bioactive volatile components that are classified into two major groups: terpenes and aromatic compounds [40]. Bioactive components may adhere to the surface of the cell and then penetrate the bacterial membranes, impairing the structural integrity and metabolism of the cell [40,41]. The cinnamon (Cinnamomum zeylanycum Boiss.) essential oil (CEO), a member of the Lauraceae family native to southern Asia, has the highest antibacterial activity of all EOs of Lauraceae plants [12,42,43]. Zhang et al. [44] and Syafiq et al. [29] found that the extract solution containing CEO inhibited the growth of E. coli and S. aureus and revealed high antibacterial activity for biopolymer packaging, respectively.
Currently, there are limited studies conducted on the effects of types and concentration of plasticizers on the films of sugar palm nanocellulose reinforced SPS/CEO bionanocomposite. Thus, this study aims to investigate the effects of different plasticizer types (glycerol, sorbitol, and glycerol/sorbitol) and concentrations (1.5, 3.0, and 4.5 wt%) on the mechanical, physical, and antibacterial characteristics of sugar palm nanocellulose reinforced SPS/CEO bionanocomposite films.
2 Materials and methods
2.1 Materials
SPS and fibre utilized in this study were extracted from sugar palm trunks planted in Kuala Jempol, Negeri Sembilan (Malaysia). Glycerol (99% purity, food-grade) with a density of 1.26 g/cm3 and a molar mass of 92.09 g/mol and d-sorbitol plasticizers (99% purity) with a density of 1.49 g/cm3 and a molar mass of 182.17 g/mol, CEO, and Tween 80 were supplied by Evergreen Sdn. Bhd., Semenyih (Selangor, Malaysia).
2.2 Methods
2.2.1 SPS extraction and preparation
A chainsaw (Stihl, USA) was used to remove SPS from the inside stem of a mature sugar palm tree. Following that, the starch powder was washed using water that was used to extract the starch from the mixture. The mixture was then filtered through a sieve (<300 µm), with the fibre remaining at the top of the sieve and the starch granules flowing into the container with the water. Separating the starch from water required slow pouring of the water so that the starch would not drain out. The by-product of the process was the fibre that was removed from the wet starch. Next, the wet starch was sun-dried for 30 min following oven drying for 24 h at 120°C [45].
2.2.2 Preparation of sugar palm nanocellulose/SPS/CEO bionanocomposite films
The sugar palm-based films were prepared by the conventional solution-casting method. The plasticizers used were glycerol (G), sorbitol (S), and their 1:1 combination ratio (GS) to study the effect of each plasticizer on SPS films. To begin with, a gelatinized SPS with 10% wt aqueous dispersion was prepared via heating of the film-forming solution for 15 min at a temperature of 95 ± 2°C in a hot water bath with constant stirring, a crucial step to disintegrate starch granules to obtain a homogenous solution. Next, different plasticizers at 0, 1.5, 3.0, or 4.5% (w/w, starch basis) were added to the dispersion (Table 1). The solution was further heated for 15 min at 95 ± 2°C. Next, cinnamon EO, SPS nanocellulose, and emulsifier (Tween 80) were added into the dispersions at 2, 0.05, and 0.05 wt%, respectively. Then, the solution was placed in a sonicator (VCX 500-W, Vibra-Cell™, USA) for 30 min using 50% amplitude and 05 pulse to disperse the SPS nanocellulose. Then, the heating process was continued for 15 min at 95°C. Before casting the film-forming solutions in glass Petri dishes, they were allowed to cool to room temperature. The glass Petri dishes were used as the casting surfaces that provided a smooth and flat surface for the film formation. The newly casted films were dried in an oven (Lab Companion Oven, Model: ON-11E, Korea) (40°C). The preparation of all films was conducted in triplicate. Upon the completion of drying for 24 h, the films were removed from the Petri dishes and placed at 53 ± 1% relative humidity (RH) in desiccators. Figure 1 shows the flowchart of preparing the bionanocomposite film.
Formulation of plasticizer used in the preparation of bionanocomposite films
| Samples | Plasticizer type | Plasticizer concentration (wt%) |
|---|---|---|
| SPS | — | 0 |
| G1.5 | Glycerol | 1.5 |
| G3.0 | Glycerol | 3.0 |
| G4.5 | Glycerol | 4.5 |
| S1.5 | Sorbitol | 1.5 |
| S3.0 | Sorbitol | 3.0 |
| S4.5 | Sorbitol | 4.5 |
| GS1.5 | Glycerol/sorbitol | 1.5:1.5 |
| GS3.0 | Glycerol/sorbitol | 3.0:3.0 |
| GS4.5 | Glycerol/sorbitol | 4.5:4.5 |

Processing flowchart of the bionanocomposite films.
2.2.3 Film thickness
The film thickness was measured using a digital micrometre (Mitutoyo Co., Japan) with 0.001 mm sensitivity. Five different areas of each film were used to obtain the thickness. The final thickness was recorded as the value of the mean measurements of each film.
2.2.4 Density and physical appearance
A densimeter (Mettler-Toledo (M) Sdn. Bhd., Shah Alam, Selangor, Malaysia) was employed for the density measurement of the prepared films. The physical appearance of the bionanocomposite films was evaluated based on their transparency, rigidity, brittleness, flexibility, and difficulty in peeling the bionanocomposite films. Xylene was used as the immersing liquid to substitute distilled water to prevent uptake of water by the hydrophilic films. Additionally, the liquid must have a lower density than the film to prevent the film from floating, making xylene the best option. Each film sample was weighed (m) prior to the xylene immersion and the volume of xylene displaced after the immersion was denoted V. The test was conducted in quadruplicate for each sample. The density (ρ) was calculated as follows:
2.2.5 Water content
The term “water content” refers to the amount of water contained within a material. The water uptake capacities of the films were determined in accordance with ASTM D 644 [46]. The initial film weight (W i) was recorded and the film was oven-dried for 24 h at a temperature of 105°C. Upon completion, the dried sample was reweighed, obtaining the final weight (W f). The weight loss percentage from the drying process was determined using equation (2). The mean value of the water content from 10 specimen sets was calculated.
2.2.6 Mechanical properties
All samples were stored in a climate-controlled room at a temperature of 23 ± 2°C and RH of 53 ± 1% for 72 h or until a steady weight within 2% weight changes was obtained. The tensile properties of the samples were determined using an Instron 3365 universal testing machine (High Wycombe, England) equipped with a 30 kg loading cell. The elongation at break and the tensile strength of 10 mm × 70 mm samples were determined in accordance with the standard technique of ASTM D 882-02 [47]. A 2 mm/min crosshead speed was used to pull the film strips. The average measurement value from 10 film samples was calculated.
2.2.7 Antibacterial activity using disc diffusion method (DDM) and agar disc method (ADM)
Three samples were chosen for plastic packaging after considering the optimum elongation at break, the tensile strength and modulus, and low water content and density. This test was carried out in triplicate. The antibacterial activity was determined using two bacteria strains: (a) Gram-positive Bacillus subtilis B29 (B. subtilis) and (b) Gram-negative Escherichia coli ATCC 2592 (E. coli). Both of the strains were supplied by the Laboratory of Molecular Biomedicine, Institute of Bioscience, Universiti Putra Malaysia, Serdang, Malaysia. The antibacterial activity of the films was determined using ADM, in which films were punched into 6 mm size using a sterile paper puncher. After that, the films were immersed in 0.5 mL of McFarland broth standard agar at a concentration of 1 × 108 CFU/mL. All samples were cultured in a variety of microbes that completely covered the plate’s surface. The plates were then inverted and incubated at 37°C for 24 h. After the incubation was completed, the inhibition zone was measured.
The CEO was tested with two other types of EOs, rosemary, and eucalyptus, to determine the inhibition zone using DDM. About 20 µL of the EO was dropped onto a 6 mm paper disc to inhibit the two types of bacteria, B. subtilis and E. coli. The disc was then placed onto the plate that was spread with the bacteria. The plates were incubated for 24 h at a temperature of 37°C. The inhibition zones were photographed and the diameters were measured.
2.2.8 Statistical analysis
Duncan’s multiple range test was employed to perform the comparison of the mean at a 0.05 significance level (p < 0.05) by using SPSS software to determine the analysis of variance (ANOVA) on the experimental findings. The test was conducted in triplicate unless otherwise stated. The significance of the added EOs based on the inhibition area was determined using ANOVA.
3 Results and discussion
3.1 Film thickness
Figure 2 shows the increase in the film thickness from 0.118 to 0.206 mm, 0.104 to 0.204 mm, and 0.12 to 0.202 mm, resulting from the increase in G, S, and GS concentrations from 1.5 to 4.5 wt%, respectively. Increasing the plasticizer concentration resulted in a considerable increase in the film thickness, depending on the plasticizer type. This could be due to the involvement of plasticizers in dissolving and structuring intermolecular polymer chain networks, resulting in greater free volumes and thus thicker films. A similar plasticizer concentration effect on the film thickness was described by Sanyang et al. [7], Syafiq et al. [1], Razavi et al. [48], Hazrol et al. [49], and Ilyas et al. [27]. Furthermore, using different plasticizer types revealed a significant effect on the film thickness, as presented in Figure 2. S-plasticized films were thicker than G-plasticized films, while GS-plasticized films were the thickest for a concentration of 1.5 wt%. The changes in the film thickness using various plasticizers could be attributed to their molar masses since the formulation of the film-forming solution was constant. G-plasticized (molar mass” 92.09 g/mol) films possessed a lower film thickness than the S-plasticized (molar mass 182.17 g/mol) films at a constant concentration, which could be due to the lower molar mass of the G-plasticizer. Sanyang et al. [7], Aitboulahsen et al. [6], and Ghasemlou et al. [50] also found that S-plasticized films produce higher thickness than the G-plasticized films.

Thickness of the samples.
3.2 Density of bionanocomposite films
Figure 3 shows the effects of the plasticizer type and concentration on the density of SPS films incorporated with the CEO. Increasing the concentration of plasticizers from 1.5 to 4.5 wt% caused a partial decrease in the density of S- (2.085−1.864 g/cm3), G- (2.038−0.990 g/cm3), and GS-plasticized films (2.233−1.822 g/cm3). It was clear that increasing the amount of plasticizers from 1.5 to 4.5 wt% decreased the density of the films significantly regardless of the plasticizer type. The findings of G-plasticized films were aligned with those described by Sanyang et al. [7], Sahari et al. [26], and Hazrol et al. [49], who plasticized SPS with glycerol, sorbitol, and glycerol/sorbitol at a 1:1 ratio.

Density of bionanocomposite films.
The density values amongst the various plasticizer types did not show much of a difference. However, at the same plasticizer concentration, the order of density reduction is as follows: GS > S > G-plasticized films. The changes in the density and molecular weight of the plasticizers might be ascribed to this phenomenon. The molecular weight of the plasticizers followed a similar reduction pattern with density. Thakur et al. [51], who researched the factor that affected the properties of the starch-based film, reported that increasing the content of glycerol in starches slowed crystallization kinetics, resulting in low density.
Figure 4a and b and Table 2 show the images and describe the visual appearance of the obtained bionanocomposite films with and without a plasticizer. It was observed that all films were slightly brownish in colour and clearly transparent (Figure 4a and b). Bionanocomposite films without plasticizers were wavy, brittle, fragile, and rigid (Figure 4a). Many cracks were also observed on the surface of bionanocomposite films without a plasticizer (Figure 4a). It was also hard to be peeled off and handle because it broke into small pieces. Strong inter/intramolecular hydrogen bonds of SPS provided less mobility to the macromolecular chains, causing the film to be cracked, rigid, and brittle [7,27]. This result was in agreement with Hazrati et al. [52], Hazrol et al. [49], and Tarique et al. [53], who studies bionanocomposite films from Dioscorea hispida, corn, and arrowroot (Maranta arundinacea) starches, respectively.

(a) SPS film without a plasticizer and (b) sugar palm bionanocomposites with a plasticizer. (c) Mechanism of reinforcement and the role of plasticizers.
Description of bionanocomposite films with and without a plasticizer
| Samples | Description of films |
|---|---|
| SPS | Clear transparent, cracked, broke into pieces, brittle and fragile, difficult to peel, and rigid |
| G1.5 | Clear transparent, not fragile, not brittle, no cracks, flexible, not sticky, and peelable |
| G3.0 | Clear transparent, more flexible than G1.5, and slightly sticky |
| G4.5 | Clear transparent, more flexible than G3.0, slightly elastic, sticky, and easy to peel |
| S1.5 | More transparent than G1.5 and GS1.5, brittle and fragile, less flexible than G1.5, not sticky, and slightly difficult to peel |
| S3.0 | More transparent than G3.0 and GS3.0, not brittle and fragile, more flexible than S1.5 but less than G3.0, not sticky, and peelable |
| S4.5 | More transparent than G4.5 and GS4.5, not brittle and fragile, flexible, not sticky, peelable, and easy to handle |
| GS1.5 | Transparent, not brittle and fragile, not rigid, flexible, peelable, and not sticky |
| GS3.0 | Transparent, more flexible than G3.0, and stickier than G3.0 |
| GS4.5 | Transparent, more flexible than G4.5, and stickier than G3.0 and G4.5 |
The use of plasticizers altered SPS films to become more flexible with smooth and homogenous surfaces (Figure 4b). SPS films with 4.5 wt% plasticizers were found to be more flexible than the film with a lower plasticizer concentration. The flexibility reduced as the plasticizer concentration decreased. The low molecular weight of plasticizers allowed them to creep into the polymer chains’ intermolecular gaps, weakening intermolecular hydrogen bonds and enhancing molecular mobility. As the plasticizer concentration increased from 1.5 to 4.5 wt%, the intermolecular hydrogen bonds of SPS films deteriorated. Nevertheless, changes in the plasticizer type had a considerable impact on the flexibility of their resultant films at similar plasticizer concentrations. Consequently, GS-plasticized bionanocomposite films revealed higher flexibility than G- and S-plasticized films. Figure 4c. shows the mechanism of reinforcement and the role of plasticizers in bionanocomposite films.
3.3 Moisture content
Figure 5 shows the significant moisture content increase as the plasticizer concentration was increased from 1.5 to 4.5 wt%, except for the S-plasticized films. In general, as the concentration of the plasticizer increases, starch-based films become more hydrophilic. Thus, several studies have demonstrated that increasing the amount of the plasticizer in hydrocolloid films increased the moisture content [7,50]. Even so, sorbitol had a lesser influence on the moisture content of SPS films for the S-plasticized films. Figure 5 illustrates the stable moisture content of G- and GS-plasticized films as the plasticizer concentrations were increased, which was in line with the findings from Sanyang et al. [7] and Aguirre et al. [54]. The lower moisture content of S-plasticized films in comparison to glycerol-containing films (e.g. G-and GS-plasticized films) could be explained by the high similarity in the molecular structure of glucose units to sorbitol, resulting in stronger molecular interactions between the intermolecular polymer chains and sorbitol. As a result, the possibility for sorbitol interaction with water molecules had decreased. On the other hand, glycerol’s hydroxyl groups had a strong affinity for water molecules, allowing glycerol-containing films to easily hold water by forming hydrogen bonds within their matrix [7,55]. As a result, glycerol functions as a water-binding agent, whereas sorbitol has a lower affinity for water molecules.

Water content of the samples.
3.4 Mechanical properties
Figures 6 and 7 and and 8 illustrate the mechanical properties of G-, S- and GS-plasticized films, respectively. A lower plasticizer concentration of 1.5 wt% resulted in high tensile strength of 12.37 MPa for G-plasticized films, 12.26 MPa for S-plasticized films, and 8.75 MPa for GS-plasticized films. The high tensile strengths at low plasticizer concentrations could be explained by the dominance of stronger hydrogen bonds established by a starch–starch intermolecular interaction over starch–plasticizer attraction. However, adding plasticizers at concentrations ranging from 1.5 to 4.5 wt% resulted in a substantial decrease in the films’ tensile strength regardless of the type of plasticizer. The tensile strength of the G-plasticized films decreased significantly from 12.37 to 2.20 MPa, while that of the S-plasticized films decreased from 12.26 to 2.20 MPa as the plasticizer concentration was increased from 1.5 to 4.5 wt%. The films’ tensile strength decreased from 8.75 to 0.83 MPa in the case of GS-plasticized films at the same plasticizer concentration range. Numerous authors reported a decrease in the tensile strength of starch-based films as the plasticizer concentration increased [11,56,57]. This phenomenon was a result of the plasticizers’ role in weakening the strong intramolecular attraction between the starch molecules chain, thereby promoting the hydrogen bond formation between starch molecules and plasticizers. Thus, it weakened the hydrogen bonds between starch chains, lowering the tensile strength of SPS plasticized films [11,58].

Mechanical properties of G-plasticized films.

Mechanical properties of S-plasticized films.

Mechanical properties of GS-plasticized films.
When the concentration of glycerol was increased from 1.5 to 4.5 wt%, the G-plasticized films demonstrated the highest decrease in the tensile strength than S- and GS-plasticized films. These findings indicated that glycerol was more effective at plasticizing SPS films than sorbitol. Sanyang et al. [11], Razavi et al. [48], and Muscat et al. [57] reported parallel findings that glycerol caused a greater decrease in the tensile strength than other polyols. This tendency could be associated with the a lower molar mass of 92.0928 g/mol of glycerol compared to sorbitol of 182 g/mol that facilitated easier glycerol–starch molecular chains interaction. Sanyang et al. [7] Tapia-Blácido et al. [59] also stated that a more effective plasticizer for the majority of edible films is glycerol.
The extendibility of a film’s length from its starting length to the breaking point is known as elongation at break, which is also known as the films’ ability to deform before breaking [11,60]. This parameter (E%) is used to calculate a film’s flexibility and stretchability. Flexibility requirements for biopackaging films vary according to their intended use and subsequent transit, handling, and storage of packed food products. The effect of plasticizer concentration (1.5–4.5 wt%) on the elongation of SPS plasticized films was inversely proportional to the films’ tensile strength. As expected, increasing the plasticizer concentration from 1.5 to 4.5 wt% resulted in a remarkable increase in film elongation: 11.46–33.94% for G-plasticized films and 3.12–40.84% for S-plasticized films. Meanwhile, GS-plasticized film experienced a slight reduction from 29.72 to 27.02%. Similar film elongation phenomena were reported by Sanyang et al. [11], Kurt and Kahyaoglu [61], and Suppakul et al. [62]. The observed increase in the film elongation might be due to plasticizers weakening the intermolecular connections between amylose, amylopectin, and amylose–amylopectin molecules in the starch matrix and substituting hydrogen bonds established between plasticizer and starch molecules. The disruption and reconstruction of starch molecular chains might reduce the rigidity and promote films’ flexibility by allowing more chain mobility.
The Young’s modulus in Figures 6–8 shows the significant film stiffness’ determinant. The stiffness of a bionanocomposite film is proportional to its Young’s modulus; the high modulus is associated with high stiffness. Films with a higher concentration of the plasticizer showed lower Young’s moduli, which showed lower stiffness. Previously, several studies observed a decrease in stiffness when the hydrophilic concentration of the plasticizer was increased in the films [49,52,63]. This phenomenon could be explained by the changes in the structure of the starch network as plasticizers were added, causing the film matrix to become less compact [11,53]. This also clarified the considerable decrease in the tensile strength and modulus observed in all bionanocomposite films as plasticizer concentrations were increased from 1.5 to 3.0 wt%, with a maximum of 4.5 wt%.
3.5 Antibacterial activity using DDM and ADM
Antibacterial activity testing is required to study membrane activity against pathogen bacteria for various applications. To make a comparison of the effectiveness of the CEO, two other EOs (rosemary and eucalyptus) were also tested for the inhibition zone. In Figure 9a (B. subtilis) and 9b (E. coli) show the antibacterial effect of the EOs towards the B. subtilis and E. coli bacteria. The presence of phenolic (cinnamaldehyde) compounds has been linked to EOs’ antibacterial action [41]. About 20 µL of CEO could inhibit E. coli and B. subtilis bacteria resulting in 20.39 and 16.30 mm inhibition diameter, on average, respectively (Table 3). The CEO showed the highest inhibition activity compared to rosemary and eucalyptus EOs. The various inhibitory effects of EOs might be due to the biological characteristics of their major constituents. The most important constituent in CEO was cinnamaldehyde while the major constituents in eucalyptus and rosemary EOs were 1,8-cineol/α-pinene and 1,8-cineol/α-pinene/camphor, respectively.
(a) Image of inhibition zone against B. subtilis and (b) inhibition zone against E. coli.
Data of inhibition zone for 3 EOs against B. subtilis and E. coli
| EOs | Test strain | |
|---|---|---|
| Inhibition zone (mm) | ||
| B. subtilis (B29) (a.) | E. coli (ATCC25922) (b.) | |
| Cinnamon | 16.30 | 20.39 |
| Rosemary | 11.27 | 11.35 |
| Eucalyptus | 10.44 | 13.22 |
Three samples of bionanocomposite films were chosen to test the inhibition zone, which were the mixture of G1.5, S1.5, and GS 1.5. The antibacterial performance of the films and the EOs were evaluated against B. subtilis and E. coli via ADM and DDM. Table 3 shows the inhibition zone of bionanocomposite films for B. subtilis and E. coli. Table 4 presents the inhibition zone of the films on B. subtilis and E. coli. According to the different types of plasticizers that were chosen, all samples showed no significant change of their inhibition zones, which were in the range of 6.82–6.85 mm for E. coli and 3.32–3.35 mm for B. subtilis. The antibacterial activity of bionanocomposite films was not significantly affected by the various types of plasticizers, which showed the same range of inhibition as showed by Syafiq et al. [1], Ghoshal et al. [64] and El Fawal et al. [65], who researched bionanocomposites incorporated with cinnamon, eucalyptus, and rosemary EOs, respectively.
Data of inhibition zone for three selected bionanocomposite films incorporated with CEO
| Sample(s) | Test strain | |
|---|---|---|
| Inhibition zone (mm) | ||
| E. coli (ATCC25922) | B. subtilis (B29) | |
| 1 (G1.5) | 6.82 | 3.35 |
| 2 (S1.5) | 6.83 | 3.32 |
| 3 (GS1.5) | 6.85 | 3.34 |
4 Conclusion
The effects of various plasticizer types and concentrations on the physical, mechanical, and antibacterial properties of sugar palm nanocellulose/SPS/CEO bionanocomposite films were studied. SPS films were brittle, with many visible cracks, and were hard to be peeled off the casting surfaces without a plasticizer. Therefore, the introduction of plasticizers aided to overcome the brittleness and improve the flexibility and peelable ability of SPS films. The findings revealed that the concentration and type of the plasticizer influenced the density, thickness, tensile strength, moisture content, surface structure, and elongation at the break of the films. The antibacterial activity of the bionanocomposite films was not significantly influenced by the type of the plasticizer, which showed that the effectiveness of the inhibition zone was maintained. Gradual increase in the plasticizer concentration from 1.5 to 4.5 wt% decreased the films’ density but increased the moisture content and thickness of the films, irrespective of the plasticizer type used. Overall, GS-plasticized films demonstrated the best performance in terms of physical and mechanical properties. The plasticizing effect of various concentrations of the plasticizer was attributable to the weakening of hydrogen bonds between the starch intermolecular chains caused by the development of starch (amylose)–plasticizer complexes. At a concentration of 4.5 wt% plasticizer, an antiplasticization effect was found for the G- and GS-plasticized films, whereas plasticization behaviour was observed at lower concentrations of the plasticizer. Fascinatingly, GS-plasticized films improved the G-plasticized films’ tensile strength while reducing S-plasticized films’ brittleness. Sugar palm nanocellulose/SPS/CEO bionanocomposite films plasticized using a mix of glycerol and sorbitol achieved optimum physical, mechanical, and antibacterial performance. However, the effects of different plasticizer types and concentrations on the solubility, water absorption, water vapour permeability, and barrier characteristics of SPS-based films should be investigated to discover the optimal combination to develop biodegradable food packaging films.
Acknowledgements
The authors would like to thank the Ministry of Higher Education Malaysia through Grant scheme Inisiatif Pemerkasaan Penerbitan Jurnal Tahun 2020 (Vot number: 9044033), HICoE (6369107), Fundamental Research Grant Scheme (FRGS): FRGS/1/2017/TK05/UPM/01/1(5540048), and Special Graduate Research Assistantship (SGRA) Geran Putra Berimpak (GPB), UPM/800-3/3/1/GPB/2019/9679800.
-
Funding information: Ministry of Higher Education Malaysia Grant Scheme Inisiatif Pemerkasaan Penerbitan Jurnal Tahun 2020 (Vot number: 9044033), HICoE (6369107), Fundamental Research Grant Scheme (FRGS): FRGS/1/2017/TK05/UPM/01/1 (5540048), and Special Graduate Research Assistantship (SGRA) Geran Putra Berimpak (GPB), UPM/800-3/3/1/GPB/2019/9679800.
-
Author contributions: All authors have accepted responsibility for the entire content of this manuscript and approved its submission.
-
Conflict of interest: The authors state no conflict of interest.
References
[1] Syafiq RM, Sapuan SM, Zuhri MRM. Effect of cinnamon essential oil on morphological, flammability and thermal properties of nanocellulose fibre–reinforced starch biopolymer composites. Nanotechnol Rev. 2020 Nov 29;9(1):1147–59.10.1515/ntrev-2020-0087Search in Google Scholar
[2] Nazrin A, Sapuan SM, Zuhri MYM, Tawakkal ISMA, Ilyas RA. Water barrier and mechanical properties of sugar palm crystalline nanocellulose reinforced thermoplastic sugar palm starch (TPS)/poly(lactic acid) (PLA) blend bionanocomposites. Nanotechnol Rev. 2021;10(1):431–2.10.1515/ntrev-2021-0033Search in Google Scholar
[3] Ilyas RA, Sapuan SM, Sanyang ML, Ishak MR, Zainudin ES. Nanocrystalline cellulose as reinforcement for polymeric matrix nanocomposites and its potential applications: a review. Curr Anal Chem. 2018 May 7;14(3):203–5.10.2174/1573411013666171003155624Search in Google Scholar
[4] Ilyas RA, Sapuan SM, Ibrahim R, Abral H, Ishak MR, Zainudin ES, et al. Effect of sugar palm nanofibrillated celluloseconcentrations on morphological, mechanical andphysical properties of biodegradable films basedon agro-waste sugar palm (Arenga pinnata(Wurmb.) Merr) starch. J Mater Res Technol. 2019;8(5):4819–30.10.1016/j.jmrt.2019.08.028Search in Google Scholar
[5] Abral H, Atmajaya A, Mahardika M, Hafizulhaq F, Kadriadi, Handayani D, et al. Effect of ultrasonication duration of polyvinyl alcohol (PVA) gel on characterizations of PVA film. J Mater Res Technol. 2020 Mar;9(2):2477–86.10.1016/j.jmrt.2019.12.078Search in Google Scholar
[6] Aitboulahsen M, El Galiou O, Laglaoui A, Bakkali M, Hassani, Zerrouk M. Effect of plasticizer type and essential oils on mechanical, physicochemical, and antimicrobial characteristics of gelatin, starch, and pectin-based films. J Food Process Preserv. 2020;44(6):1–10.10.1111/jfpp.14480Search in Google Scholar
[7] Sanyang ML, Sapuan SM, Jawaid M, Ishak MR, Sahari J. Effect of plasticizer type and concentration on physical properties of biodegradable films based on sugar palm (Arenga pinnata) starch for food packaging. J Food Sci Technol. 2016;53(January):326–36.10.1007/s13197-015-2009-7Search in Google Scholar PubMed PubMed Central
[8] Aisyah HA, Paridah MT, Sapuan SM, Ilyas RA, Khalina A, Nurazzi NM, et al. A comprehensive review on advanced sustainable woven natural fibre polymer composites. Polym (Basel). 2021 Feb;13(3):471.10.3390/polym13030471Search in Google Scholar PubMed PubMed Central
[9] Hassan B, Chatha SAS, Hussain AI, Zia KM, Akhtar N. Recent advances on polysaccharides, lipids and protein based edible films and coatings: a review. Int J Biol Macromol. 2018;109:1095–7.10.1016/j.ijbiomac.2017.11.097Search in Google Scholar PubMed
[10] Alsubari S, Zuhri MYM, Sapuan SM, Ishak MR, Ilyas RA, Asyraf MRM. Potential of natural fiber reinforced polymer composites in sandwich structures: a review on its mechanical properties. Polym (Basel). 2021;13(3):423.10.3390/polym13030423Search in Google Scholar PubMed PubMed Central
[11] Sanyang ML, Sapuan SM, Jawaid M, Ishak MR, Sahari J. Effect of plasticizer type and concentration on tensile, thermal and barrier properties of biodegradable films based on sugar palm (Arenga pinnata) starch. Polym (Basel). 2015;7(6):1106–24.10.3390/polym7061106Search in Google Scholar
[12] Syafiq R, Sapuan SM, Zuhri MYM, Ilyas RA, Nazrin A, Sherwani SFK, et al. Antimicrobial activities of starch-based biopolymers and biocomposites incorporated with plant essential oils: a review. Polym (Basel). 2020;12(10):1–26.10.3390/polym12102403Search in Google Scholar PubMed PubMed Central
[13] Ilyas RA, Sapuan SM, Ishak MR. Isolation and characterization of nanocrystalline cellulose from sugar palm fibres (Arenga Pinnata). Carbohydr Polym. 2018;181(November 2017):1038–51.10.1016/j.carbpol.2017.11.045Search in Google Scholar PubMed
[14] Mohd Nurazzi N, Asyraf MRM, Khalina A, Abdullah N, Sabaruddin FA, Kamarudin SH, et al. Fabrication, functionalization, and application of carbon nanotube-reinforced polymer composite: an overview. Polym (Basel). 2021 Mar;13(7):1047.10.3390/polym13071047Search in Google Scholar PubMed PubMed Central
[15] Maniglia BC, Tessaro L, Ramos AP, Tapia-Blácido DR. Which plasticizer is suitable for films based on babassu starch isolated by different methods. Food Hydrocoll. 2019;89(October 2018):143–52.10.1016/j.foodhyd.2018.10.038Search in Google Scholar
[16] Ivanič F, Jochec-Mošková D, Janigová I, Chodák I. Physical properties of starch plasticized by a mixture of plasticizers. Eur Polym J. 2017;93:843–9.10.1016/j.eurpolymj.2017.04.006Search in Google Scholar
[17] Ayu RS, Khalina A, Harmaen AS, Zaman K, Isma T, Liu Q, et al. Characterization study of empty fruit bunch (EFB) fibers reinforcement in poly(butylene) succinate (PBS)/starch/glycerol composite sheet. Polym (Basel). 2020 Jul;12(7):1571.10.3390/polym12071571Search in Google Scholar PubMed PubMed Central
[18] Nurazzi NM, Asyraf MRM, Khalina A, Abdullah N, Aisyah HA, Rafiqah SA, et al. A review on natural fiber reinforced polymer composite for bullet proof and ballistic applications. Polym (Basel). 2021 Feb;13(4):646.10.3390/polym13040646Search in Google Scholar PubMed PubMed Central
[19] Tunç S, Duman O, Polat TG. Effects of montmorillonite on properties of methyl cellulose/carvacrol based active antimicrobial nanocomposites. Carbohydr Polym. 2016;150:259–68. 10.1016/j.carbpol.2016.05.019.Search in Google Scholar PubMed
[20] Tunç S, Duman O. Preparation and characterization of biodegradable methyl cellulose/montmorillonite nanocomposite films. Appl Clay Sci. 2010;48(3):414–24. 10.1016/j.clay.2010.01.016.Search in Google Scholar
[21] Tunç S, Duman O. Preparation of active antimicrobial methyl cellulose/carvacrol/montmorillonite nanocomposite films and investigation of carvacrol release. LWT – Food Sci Technol. 2011;44(2):465–72. 10.1016/j.lwt.2010.08.018.Search in Google Scholar
[22] Hazrol MD, Sapuan SM, Ilyas RA, Othman ML, Sherwani SFK. Electrical properties of sugar palm nanocrystalline cellulose reinforced sugar palm starch nanocomposites. Polimery. 2020 May;65(5):363–70.10.14314/polimery.2020.5.4Search in Google Scholar
[23] Nazrin A, Sapuan SM, Zuhri MYM, Ilyas RA, Syafiq RSFKS. Nanocellulose reinforced thermoplastic starch (TPS), polylactic acid (PLA), and polybutylene succinate (PBS) for food packaging applications. Front Chem. 2020;8:213.10.3389/fchem.2020.00213Search in Google Scholar PubMed PubMed Central
[24] Omran AAB, Mohammed AABA, Sapuan SM, Ilyas RA, Asyraf MRM, Koloor SSR, et al. Micro- and nanocellulose in polymer composite materials: a review. Polym (Basel). 2021 Jan;13(2):231.10.3390/polym13020231Search in Google Scholar PubMed PubMed Central
[25] Adawiyah DR, Sasaki T, Kohyama K. Characterization of arenga starch in comparison with sago starch. Carbohydr Polym. 2013;92(2):2306–13.10.1016/j.carbpol.2012.12.014Search in Google Scholar PubMed
[26] Sahari J, Sapuan SM, Zainudin ES, Maleque MA. A new approach to use arenga pinnata as sustainable biopolymer: effects of plasticizers on physical properties. Proc Chem. 2012;4:254–9.10.1016/j.proche.2012.06.035Search in Google Scholar
[27] Ilyas RA, Sapuan SM, Ishak MR, Zainudin ES. Development and characterization of sugar palm nanocrystalline cellulose reinforced sugar palm starch bionanocomposites. Carbohydr Polym. 2018;202(September):186–202.10.1016/j.carbpol.2018.09.002Search in Google Scholar PubMed
[28] Nazrin A, Sapuan SM, Zuhri MYM. Mechanical, physical and thermal properties of sugar palm nanocellulose reinforced thermoplastic starch (Tps)/poly (lactic acid) (pla) blend bionanocomposites. Polym (Basel). 2020;12(10):1–18.10.3390/polym12102216Search in Google Scholar PubMed PubMed Central
[29] Syafiq R, Sapuan SM, Zuhri MRM. Antimicrobial activity, physical, mechanical and barrier properties of sugar palm based nanocellulose/starch biocomposite films incorporated with cinnamon essential oil. J Mater Res Technol. 2021 Mar;11:144–57.10.1016/j.jmrt.2020.12.091Search in Google Scholar
[30] Diyana ZN, Jumaidin R, Selamat MZ, Ghazali I, Julmohammad N, Huda N, et al. Physical properties of thermoplastic starch derived from natural resources and its blends: a review. Polym (Basel). 2021 Apr;13(9):1–20.10.3390/polym13091396Search in Google Scholar PubMed PubMed Central
[31] Perdana MI, Ruamcharoen J, Panphon S, Leelakriangsak M. Antimicrobial activity and physical properties of starch/chitosan film incorporated with lemongrass essential oil and its application. Lwt. 2021;141(November 2020):110934.10.1016/j.lwt.2021.110934Search in Google Scholar
[32] Ilyas RA, Sapuan SM. Biopolymers and biocomposites: chemistry and technology. Curr Anal Chem. 2020 Jul;16(5):500–3.10.2174/157341101605200603095311Search in Google Scholar
[33] Zhang Y, Rempel C, Liu Q. Thermoplastic starch processing and characteristics – a review. Crit Rev Food Sci Nutr. 2014;54(10):1353–70.10.1080/10408398.2011.636156Search in Google Scholar PubMed
[34] Ilyas RA, Sapuan SM, Ishak MR, Zainudin ES, Atikah MSN. Characterization of sugar palm nanocellulose and its potential for reinforcement with a starch-based composite. In Sugar palm biofibers, biopolymers, and biocomposites. 1st edn. Boca Raton: CRC Press/Taylor & Francis Group; 2018. p. 190–212.10.1201/9780429443923-10Search in Google Scholar
[35] Sari NH, Pruncu CI, Sapuan SM, Ilyas RA, Catur AD, Suteja S, et al. The effect of water immersion and fibre content on properties of corn husk fibres reinforced thermoset polyester composite. Polym Test. 2020 Nov;91:106751.10.1016/j.polymertesting.2020.106751Search in Google Scholar
[36] Ilyas RA, Sapuan SM, Harussani MM, Hakimi MYAY, Haziq MZM, Atikah MSN, et al. Polylactic acid (PLA) biocomposite: processing, additive manufacturing and advanced applications. Polym (Basel). 2021 Apr;13(8):1326.10.3390/polym13081326Search in Google Scholar PubMed PubMed Central
[37] Wińska K, Mączka W, Łyczko J, Grabarczyk M, Czubaszek A, Szumny A. Essential oils as antimicrobial agents – myth or real alternative? Molecules. 2019;24(11):1–21.10.3390/molecules24112130Search in Google Scholar PubMed PubMed Central
[38] Sánchez Aldana D, Andrade-Ochoa S, Aguilar CN, Contreras-Esquivel JC, Nevárez-Moorillón GV. Antibacterial activity of pectic-based edible films incorporated with Mexican lime essential oil. Food Control. 2015;50:907–12.10.1016/j.foodcont.2014.10.044Search in Google Scholar
[39] Mith H, Duré R, Delcenserie V, Zhiri A, Daube G, Clinquart A. Antimicrobial activities of commercial essential oils and their components against food-borne pathogens and food spoilage bacteria. Food Sci Nutr. 2014;2(4):403–16.10.1002/fsn3.116Search in Google Scholar PubMed PubMed Central
[40] Calo JR, Crandall PG, O’Bryan CA, Ricke SC. Essential oils as antimicrobials in food systems – a review. Food Control. 2015;54:111–9.10.1016/j.foodcont.2014.12.040Search in Google Scholar
[41] Chouhan S, Sharma K, Guleria S. Antimicrobial activity of some essential oils–present status and future perspectives. Medicines. 2017 Aug;4(3):58.10.3390/medicines4030058Search in Google Scholar
[42] Lu F, Ding YC, Ye XQ, Ding YT. Antibacterial effect of cinnamon oil combined with thyme or clove oil. Agric Sci China. 2011;10(9):1482–7.10.1016/S1671-2927(11)60142-9Search in Google Scholar
[43] Raeisi M, Tajik H, Yarahmadi A, Sanginabadi S. Antimicrobial effect of cinnamon essential oil against Escherichia coli and Staphylococcus aureus. Heal Scope. 2015;4(4):1–4.10.17795/jhealthscope-21808Search in Google Scholar
[44] Zhang Y, Liu X, Wang Y, Jiang P, Quek SY. Antibacterial activity and mechanism of cinnamon essential oil against Escherichia coli and Staphylococcus aureus. Food Control. 2016;59:282–9.10.1016/j.foodcont.2015.05.032Search in Google Scholar
[45] Sahari J, Sapuan SM, Zainudin ES, Maleque MA. Thermo-mechanical behaviors of thermoplastic starch derived from sugar palm tree (Arenga pinnata). Carbohydr Polym. 2013;92(2):1711–6.10.1016/j.carbpol.2012.11.031Search in Google Scholar PubMed
[46] ASTM D 664. Standard test method for moisture content of paper and paperboard by oven drying. West Conshohocken, PA: ASTM International; 2002.Search in Google Scholar
[47] ASTM D882-02. Standard test method for tensile properties of thin plastic sheeting. West Conshohocken, PA: ASTM International; 2002.Search in Google Scholar
[48] Razavi SMA, Mohammad Amini A, Zahedi Y. Characterisation of a new biodegradable edible film based on sage seed gum: influence of plasticizer type and concentration. Food Hydrocoll. 2015;43:290–8.10.1016/j.foodhyd.2014.05.028Search in Google Scholar
[49] Hazrol MD, Sapuan SM, Zainudin ES, Zuhri MYM, Wahab NIA. Corn starch (Zea mays) biopolymer plastic reaction in combination with sorbitol and glycerol. Polym (Basel). 2021;13(2):1–22.10.3390/polym13020242Search in Google Scholar PubMed PubMed Central
[50] Ghasemlou M, Khodaiyan F, Oromiehie A. Physical, mechanical, barrier, and thermal properties of polyol-plasticized biodegradable edible film made from kefiran. Carbohydr Polym. 2011;84(1):477–83.10.1016/j.carbpol.2010.12.010Search in Google Scholar
[51] Thakur R, Pristijono P, Scarlett CJ, Bowyer M, Singh SP, Vuong QV. Starch-based films: major factors affecting their properties. Int J Biol Macromol. 2019;132:1079–89.10.1016/j.ijbiomac.2019.03.190Search in Google Scholar PubMed
[52] Hazrati KZ, Sapuan SM, Zuhri MYM, Jumaidin R. Effect of plasticizers on physical, thermal, and tensile properties of thermoplastic films based on Dioscorea hispida starch. Int J Biol Macromol. 2021;185(January):219–8.10.1016/j.ijbiomac.2021.06.099Search in Google Scholar PubMed
[53] Tarique J, Sapuan SM, Khalina A. Effect of glycerol plasticizer loading on the physical, mechanical, thermal, and barrier properties of arrowroot (Maranta arundinacea) starch biopolymers. Sci Rep. 2021;11(1):1–17.10.1038/s41598-021-93094-ySearch in Google Scholar PubMed PubMed Central
[54] Aguirre A, Borneo R, León AE. Properties of triticale protein films and their relation to plasticizing-antiplasticizing effects of glycerol and sorbitol. Ind Crop Prod. 2013;50:297–303.10.1016/j.indcrop.2013.07.043Search in Google Scholar
[55] Cerqueira MA, Souza BWS, Teixeira JA, Vicente AA. Effect of glycerol and corn oil on physicochemical properties of polysaccharide films – a comparative study. Food Hydrocoll. 2012;27(1):175–84.10.1016/j.foodhyd.2011.07.007Search in Google Scholar
[56] Jouki M, Khazaei N, Ghasemlou M, Hadinezhad M. Effect of glycerol concentration on edible film production from cress seed carbohydrate gum. Carbohydr Polym. 2013;96(1):39–46.10.1016/j.carbpol.2013.03.077Search in Google Scholar PubMed
[57] Muscat D, Adhikari B, Adhikari R, Chaudhary DS. Comparative study of film forming behaviour of low and high amylose starches using glycerol and xylitol as plasticizers. J Food Eng. 2012;109(2):189–201.10.1016/j.jfoodeng.2011.10.019Search in Google Scholar
[58] Adhikari B, Chaudhary DS, Clerfeuille E. Effect of plasticizers on the moisture migration behavior of low-amylose starch films during drying. Dry Technol. 2010;28(4):468–80.10.1080/07373931003613593Search in Google Scholar
[59] Tapia-Blácido DR, Sobral PJdA, Menegalli FC. Effect of drying conditions and plasticizer type on some physical and mechanical properties of amaranth flour films. LWT – Food Sci Technol. 2013;50(2):392–400.10.1016/j.lwt.2012.09.008Search in Google Scholar
[60] Cao L, Liu W, Wang L. Developing a green and edible film from Cassia gum: the effects of glycerol and sorbitol. J Clean Prod. 2018;175:276–82.10.1016/j.jclepro.2017.12.064Search in Google Scholar
[61] Kurt A, Kahyaoglu T. Characterization of a new biodegradable edible film made from salep glucomannan. Carbohydr Polym. 2014;104(1):50–8.10.1016/j.carbpol.2014.01.003Search in Google Scholar PubMed
[62] Suppakul P, Chalernsook B, Ratisuthawat B, Prapasitthi S, Munchukangwan N. Empirical modeling of moisture sorption characteristics and mechanical and barrier properties of cassava flour film and their relation to plasticizing-antiplasticizing effects. LWT – Food Sci Technol. 2013;50(1):290–7.10.1016/j.lwt.2012.05.013Search in Google Scholar
[63] Edhirej A, Sapuan SM, Jawaid M, Zahari NI. Effect of various plasticizers and concentration on the physical, thermal, mechanical, and structural properties of cassava-starch-based films. Starch/Staerke. 2017;69(1–2):1–11.10.1002/star.201500366Search in Google Scholar
[64] Ghoshal G, Singh D. Synthesis and characterization of starch nanocellulosic films incorporated with Eucalyptus globulus leaf extract. Int J Food Microbiol. 2020;332(June):108765.10.1016/j.ijfoodmicro.2020.108765Search in Google Scholar PubMed
[65] El Fawal GF, Omer AM, Tamer TM. Evaluation of antimicrobial and antioxidant activities for cellulose acetate films incorporated with Rosemary and Aloe Vera essential oils. J Food Sci Technol. 2019;56(3):1510–8.10.1007/s13197-019-03642-8Search in Google Scholar PubMed PubMed Central
© 2022 Razali Mohamad Omar Syafiq et al., published by De Gruyter
This work is licensed under the Creative Commons Attribution 4.0 International License.
Articles in the same Issue
- Research Articles
- Theoretical and experimental investigation of MWCNT dispersion effect on the elastic modulus of flexible PDMS/MWCNT nanocomposites
- Mechanical, morphological, and fracture-deformation behavior of MWCNTs-reinforced (Al–Cu–Mg–T351) alloy cast nanocomposites fabricated by optimized mechanical milling and powder metallurgy techniques
- Flammability and physical stability of sugar palm crystalline nanocellulose reinforced thermoplastic sugar palm starch/poly(lactic acid) blend bionanocomposites
- Glutathione-loaded non-ionic surfactant niosomes: A new approach to improve oral bioavailability and hepatoprotective efficacy of glutathione
- Relationship between mechano-bactericidal activity and nanoblades density on chemically strengthened glass
- In situ regulation of microstructure and microwave-absorbing properties of FeSiAl through HNO3 oxidation
- Research on a mechanical model of magnetorheological fluid different diameter particles
- Nanomechanical and dynamic mechanical properties of rubber–wood–plastic composites
- Investigative properties of CeO2 doped with niobium: A combined characterization and DFT studies
- Miniaturized peptidomimetics and nano-vesiculation in endothelin types through probable nano-disk formation and structure property relationships of endothelins’ fragments
- N/S co-doped CoSe/C nanocubes as anode materials for Li-ion batteries
- Synergistic effects of halloysite nanotubes with metal and phosphorus additives on the optimal design of eco-friendly sandwich panels with maximum flame resistance and minimum weight
- Octreotide-conjugated silver nanoparticles for active targeting of somatostatin receptors and their application in a nebulized rat model
- Controllable morphology of Bi2S3 nanostructures formed via hydrothermal vulcanization of Bi2O3 thin-film layer and their photoelectrocatalytic performances
- Development of (−)-epigallocatechin-3-gallate-loaded folate receptor-targeted nanoparticles for prostate cancer treatment
- Enhancement of the mechanical properties of HDPE mineral nanocomposites by filler particles modulation of the matrix plastic/elastic behavior
- Effect of plasticizers on the properties of sugar palm nanocellulose/cinnamon essential oil reinforced starch bionanocomposite films
- Optimization of nano coating to reduce the thermal deformation of ball screws
- Preparation of efficient piezoelectric PVDF–HFP/Ni composite films by high electric field poling
- MHD dissipative Casson nanofluid liquid film flow due to an unsteady stretching sheet with radiation influence and slip velocity phenomenon
- Effects of nano-SiO2 modification on rubberised mortar and concrete with recycled coarse aggregates
- Mechanical and microscopic properties of fiber-reinforced coal gangue-based geopolymer concrete
- Effect of morphology and size on the thermodynamic stability of cerium oxide nanoparticles: Experiment and molecular dynamics calculation
- Mechanical performance of a CFRP composite reinforced via gelatin-CNTs: A study on fiber interfacial enhancement and matrix enhancement
- A practical review over surface modification, nanopatterns, emerging materials, drug delivery systems, and their biophysiochemical properties for dental implants: Recent progresses and advances
- HTR: An ultra-high speed algorithm for cage recognition of clathrate hydrates
- Effects of microalloying elements added by in situ synthesis on the microstructure of WCu composites
- A highly sensitive nanobiosensor based on aptamer-conjugated graphene-decorated rhodium nanoparticles for detection of HER2-positive circulating tumor cells
- Progressive collapse performance of shear strengthened RC frames by nano CFRP
- Core–shell heterostructured composites of carbon nanotubes and imine-linked hyperbranched polymers as metal-free Li-ion anodes
- A Galerkin strategy for tri-hybridized mixture in ethylene glycol comprising variable diffusion and thermal conductivity using non-Fourier’s theory
- Simple models for tensile modulus of shape memory polymer nanocomposites at ambient temperature
- Preparation and morphological studies of tin sulfide nanoparticles and use as efficient photocatalysts for the degradation of rhodamine B and phenol
- Polyethyleneimine-impregnated activated carbon nanofiber composited graphene-derived rice husk char for efficient post-combustion CO2 capture
- Electrospun nanofibers of Co3O4 nanocrystals encapsulated in cyclized-polyacrylonitrile for lithium storage
- Pitting corrosion induced on high-strength high carbon steel wire in high alkaline deaerated chloride electrolyte
- Formulation of polymeric nanoparticles loaded sorafenib; evaluation of cytotoxicity, molecular evaluation, and gene expression studies in lung and breast cancer cell lines
- Engineered nanocomposites in asphalt binders
- Influence of loading voltage, domain ratio, and additional load on the actuation of dielectric elastomer
- Thermally induced hex-graphene transitions in 2D carbon crystals
- The surface modification effect on the interfacial properties of glass fiber-reinforced epoxy: A molecular dynamics study
- Molecular dynamics study of deformation mechanism of interfacial microzone of Cu/Al2Cu/Al composites under tension
- Nanocolloid simulators of luminescent solar concentrator photovoltaic windows
- Compressive strength and anti-chloride ion penetration assessment of geopolymer mortar merging PVA fiber and nano-SiO2 using RBF–BP composite neural network
- Effect of 3-mercapto-1-propane sulfonate sulfonic acid and polyvinylpyrrolidone on the growth of cobalt pillar by electrodeposition
- Dynamics of convective slippery constraints on hybrid radiative Sutterby nanofluid flow by Galerkin finite element simulation
- Preparation of vanadium by the magnesiothermic self-propagating reduction and process control
- Microstructure-dependent photoelectrocatalytic activity of heterogeneous ZnO–ZnS nanosheets
- Cytotoxic and pro-inflammatory effects of molybdenum and tungsten disulphide on human bronchial cells
- Improving recycled aggregate concrete by compression casting and nano-silica
- Chemically reactive Maxwell nanoliquid flow by a stretching surface in the frames of Newtonian heating, nonlinear convection and radiative flux: Nanopolymer flow processing simulation
- Nonlinear dynamic and crack behaviors of carbon nanotubes-reinforced composites with various geometries
- Biosynthesis of copper oxide nanoparticles and its therapeutic efficacy against colon cancer
- Synthesis and characterization of smart stimuli-responsive herbal drug-encapsulated nanoniosome particles for efficient treatment of breast cancer
- Homotopic simulation for heat transport phenomenon of the Burgers nanofluids flow over a stretching cylinder with thermal convective and zero mass flux conditions
- Incorporation of copper and strontium ions in TiO2 nanotubes via dopamine to enhance hemocompatibility and cytocompatibility
- Mechanical, thermal, and barrier properties of starch films incorporated with chitosan nanoparticles
- Mechanical properties and microstructure of nano-strengthened recycled aggregate concrete
- Glucose-responsive nanogels efficiently maintain the stability and activity of therapeutic enzymes
- Tunning matrix rheology and mechanical performance of ultra-high performance concrete using cellulose nanofibers
- Flexible MXene/copper/cellulose nanofiber heat spreader films with enhanced thermal conductivity
- Promoted charge separation and specific surface area via interlacing of N-doped titanium dioxide nanotubes on carbon nitride nanosheets for photocatalytic degradation of Rhodamine B
- Elucidating the role of silicon dioxide and titanium dioxide nanoparticles in mitigating the disease of the eggplant caused by Phomopsis vexans, Ralstonia solanacearum, and root-knot nematode Meloidogyne incognita
- An implication of magnetic dipole in Carreau Yasuda liquid influenced by engine oil using ternary hybrid nanomaterial
- Robust synthesis of a composite phase of copper vanadium oxide with enhanced performance for durable aqueous Zn-ion batteries
- Tunning self-assembled phases of bovine serum albumin via hydrothermal process to synthesize novel functional hydrogel for skin protection against UVB
- A comparative experimental study on damping properties of epoxy nanocomposite beams reinforced with carbon nanotubes and graphene nanoplatelets
- Lightweight and hydrophobic Ni/GO/PVA composite aerogels for ultrahigh performance electromagnetic interference shielding
- Research on the auxetic behavior and mechanical properties of periodically rotating graphene nanostructures
- Repairing performances of novel cement mortar modified with graphene oxide and polyacrylate polymer
- Closed-loop recycling and fabrication of hydrophilic CNT films with high performance
- Design of thin-film configuration of SnO2–Ag2O composites for NO2 gas-sensing applications
- Study on stress distribution of SiC/Al composites based on microstructure models with microns and nanoparticles
- PVDF green nanofibers as potential carriers for improving self-healing and mechanical properties of carbon fiber/epoxy prepregs
- Osteogenesis capability of three-dimensionally printed poly(lactic acid)-halloysite nanotube scaffolds containing strontium ranelate
- Silver nanoparticles induce mitochondria-dependent apoptosis and late non-canonical autophagy in HT-29 colon cancer cells
- Preparation and bonding mechanisms of polymer/metal hybrid composite by nano molding technology
- Damage self-sensing and strain monitoring of glass-reinforced epoxy composite impregnated with graphene nanoplatelet and multiwalled carbon nanotubes
- Thermal analysis characterisation of solar-powered ship using Oldroyd hybrid nanofluids in parabolic trough solar collector: An optimal thermal application
- Pyrene-functionalized halloysite nanotubes for simultaneously detecting and separating Hg(ii) in aqueous media: A comprehensive comparison on interparticle and intraparticle excimers
- Fabrication of self-assembly CNT flexible film and its piezoresistive sensing behaviors
- Thermal valuation and entropy inspection of second-grade nanoscale fluid flow over a stretching surface by applying Koo–Kleinstreuer–Li relation
- Mechanical properties and microstructure of nano-SiO2 and basalt-fiber-reinforced recycled aggregate concrete
- Characterization and tribology performance of polyaniline-coated nanodiamond lubricant additives
- Combined impact of Marangoni convection and thermophoretic particle deposition on chemically reactive transport of nanofluid flow over a stretching surface
- Spark plasma extrusion of binder free hydroxyapatite powder
- An investigation on thermo-mechanical performance of graphene-oxide-reinforced shape memory polymer
- Effect of nanoadditives on the novel leather fiber/recycled poly(ethylene-vinyl-acetate) polymer composites for multifunctional applications: Fabrication, characterizations, and multiobjective optimization using central composite design
- Design selection for a hemispherical dimple core sandwich panel using hybrid multi-criteria decision-making methods
- Improving tensile strength and impact toughness of plasticized poly(lactic acid) biocomposites by incorporating nanofibrillated cellulose
- Green synthesis of spinel copper ferrite (CuFe2O4) nanoparticles and their toxicity
- The effect of TaC and NbC hybrid and mono-nanoparticles on AA2024 nanocomposites: Microstructure, strengthening, and artificial aging
- Excited-state geometry relaxation of pyrene-modified cellulose nanocrystals under UV-light excitation for detecting Fe3+
- Effect of CNTs and MEA on the creep of face-slab concrete at an early age
- Effect of deformation conditions on compression phase transformation of AZ31
- Application of MXene as a new generation of highly conductive coating materials for electromembrane-surrounded solid-phase microextraction
- A comparative study of the elasto-plastic properties for ceramic nanocomposites filled by graphene or graphene oxide nanoplates
- Encapsulation strategies for improving the biological behavior of CdS@ZIF-8 nanocomposites
- Biosynthesis of ZnO NPs from pumpkin seeds’ extract and elucidation of its anticancer potential against breast cancer
- Preliminary trials of the gold nanoparticles conjugated chrysin: An assessment of anti-oxidant, anti-microbial, and in vitro cytotoxic activities of a nanoformulated flavonoid
- Effect of micron-scale pores increased by nano-SiO2 sol modification on the strength of cement mortar
- Fractional simulations for thermal flow of hybrid nanofluid with aluminum oxide and titanium oxide nanoparticles with water and blood base fluids
- The effect of graphene nano-powder on the viscosity of water: An experimental study and artificial neural network modeling
- Development of a novel heat- and shear-resistant nano-silica gelling agent
- Characterization, biocompatibility and in vivo of nominal MnO2-containing wollastonite glass-ceramic
- Entropy production simulation of second-grade magnetic nanomaterials flowing across an expanding surface with viscidness dissipative flux
- Enhancement in structural, morphological, and optical properties of copper oxide for optoelectronic device applications
- Aptamer-functionalized chitosan-coated gold nanoparticle complex as a suitable targeted drug carrier for improved breast cancer treatment
- Performance and overall evaluation of nano-alumina-modified asphalt mixture
- Analysis of pure nanofluid (GO/engine oil) and hybrid nanofluid (GO–Fe3O4/engine oil): Novel thermal and magnetic features
- Synthesis of Ag@AgCl modified anatase/rutile/brookite mixed phase TiO2 and their photocatalytic property
- Mechanisms and influential variables on the abrasion resistance hydraulic concrete
- Synergistic reinforcement mechanism of basalt fiber/cellulose nanocrystals/polypropylene composites
- Achieving excellent oxidation resistance and mechanical properties of TiB2–B4C/carbon aerogel composites by quick-gelation and mechanical mixing
- Microwave-assisted sol–gel template-free synthesis and characterization of silica nanoparticles obtained from South African coal fly ash
- Pulsed laser-assisted synthesis of nano nickel(ii) oxide-anchored graphitic carbon nitride: Characterizations and their potential antibacterial/anti-biofilm applications
- Effects of nano-ZrSi2 on thermal stability of phenolic resin and thermal reusability of quartz–phenolic composites
- Benzaldehyde derivatives on tin electroplating as corrosion resistance for fabricating copper circuit
- Mechanical and heat transfer properties of 4D-printed shape memory graphene oxide/epoxy acrylate composites
- Coupling the vanadium-induced amorphous/crystalline NiFe2O4 with phosphide heterojunction toward active oxygen evolution reaction catalysts
- Graphene-oxide-reinforced cement composites mechanical and microstructural characteristics at elevated temperatures
- Gray correlation analysis of factors influencing compressive strength and durability of nano-SiO2 and PVA fiber reinforced geopolymer mortar
- Preparation of layered gradient Cu–Cr–Ti alloy with excellent mechanical properties, thermal stability, and electrical conductivity
- Recovery of Cr from chrome-containing leather wastes to develop aluminum-based composite material along with Al2O3 ceramic particles: An ingenious approach
- Mechanisms of the improved stiffness of flexible polymers under impact loading
- Anticancer potential of gold nanoparticles (AuNPs) using a battery of in vitro tests
- Review Articles
- Proposed approaches for coronaviruses elimination from wastewater: Membrane techniques and nanotechnology solutions
- Application of Pickering emulsion in oil drilling and production
- The contribution of microfluidics to the fight against tuberculosis
- Graphene-based biosensors for disease theranostics: Development, applications, and recent advancements
- Synthesis and encapsulation of iron oxide nanorods for application in magnetic hyperthermia and photothermal therapy
- Contemporary nano-architectured drugs and leads for ανβ3 integrin-based chemotherapy: Rationale and retrospect
- State-of-the-art review of fabrication, application, and mechanical properties of functionally graded porous nanocomposite materials
- Insights on magnetic spinel ferrites for targeted drug delivery and hyperthermia applications
- A review on heterogeneous oxidation of acetaminophen based on micro and nanoparticles catalyzed by different activators
- Early diagnosis of lung cancer using magnetic nanoparticles-integrated systems
- Advances in ZnO: Manipulation of defects for enhancing their technological potentials
- Efficacious nanomedicine track toward combating COVID-19
- A review of the design, processes, and properties of Mg-based composites
- Green synthesis of nanoparticles for varied applications: Green renewable resources and energy-efficient synthetic routes
- Two-dimensional nanomaterial-based polymer composites: Fundamentals and applications
- Recent progress and challenges in plasmonic nanomaterials
- Apoptotic cell-derived micro/nanosized extracellular vesicles in tissue regeneration
- Electronic noses based on metal oxide nanowires: A review
- Framework materials for supercapacitors
- An overview on the reproductive toxicity of graphene derivatives: Highlighting the importance
- Antibacterial nanomaterials: Upcoming hope to overcome antibiotic resistance crisis
- Research progress of carbon materials in the field of three-dimensional printing polymer nanocomposites
- A review of atomic layer deposition modelling and simulation methodologies: Density functional theory and molecular dynamics
- Recent advances in the preparation of PVDF-based piezoelectric materials
- Recent developments in tensile properties of friction welding of carbon fiber-reinforced composite: A review
- Comprehensive review of the properties of fly ash-based geopolymer with additive of nano-SiO2
- Perspectives in biopolymer/graphene-based composite application: Advances, challenges, and recommendations
- Graphene-based nanocomposite using new modeling molecular dynamic simulations for proposed neutralizing mechanism and real-time sensing of COVID-19
- Nanotechnology application on bamboo materials: A review
- Recent developments and future perspectives of biorenewable nanocomposites for advanced applications
- Nanostructured lipid carrier system: A compendium of their formulation development approaches, optimization strategies by quality by design, and recent applications in drug delivery
- 3D printing customized design of human bone tissue implant and its application
- Design, preparation, and functionalization of nanobiomaterials for enhanced efficacy in current and future biomedical applications
- A brief review of nanoparticles-doped PEDOT:PSS nanocomposite for OLED and OPV
- Nanotechnology interventions as a putative tool for the treatment of dental afflictions
- Recent advancements in metal–organic frameworks integrating quantum dots (QDs@MOF) and their potential applications
- A focused review of short electrospun nanofiber preparation techniques for composite reinforcement
- Microstructural characteristics and nano-modification of interfacial transition zone in concrete: A review
- Latest developments in the upconversion nanotechnology for the rapid detection of food safety: A review
- Strategic applications of nano-fertilizers for sustainable agriculture: Benefits and bottlenecks
- Molecular dynamics application of cocrystal energetic materials: A review
- Synthesis and application of nanometer hydroxyapatite in biomedicine
- Cutting-edge development in waste-recycled nanomaterials for energy storage and conversion applications
- Biological applications of ternary quantum dots: A review
- Nanotherapeutics for hydrogen sulfide-involved treatment: An emerging approach for cancer therapy
- Application of antibacterial nanoparticles in orthodontic materials
- Effect of natural-based biological hydrogels combined with growth factors on skin wound healing
- Nanozymes – A route to overcome microbial resistance: A viewpoint
- Recent developments and applications of smart nanoparticles in biomedicine
- Contemporary review on carbon nanotube (CNT) composites and their impact on multifarious applications
- Interfacial interactions and reinforcing mechanisms of cellulose and chitin nanomaterials and starch derivatives for cement and concrete strength and durability enhancement: A review
- Diamond-like carbon films for tribological modification of rubber
- Layered double hydroxides (LDHs) modified cement-based materials: A systematic review
- Recent research progress and advanced applications of silica/polymer nanocomposites
- Modeling of supramolecular biopolymers: Leading the in silico revolution of tissue engineering and nanomedicine
- Recent advances in perovskites-based optoelectronics
- Biogenic synthesis of palladium nanoparticles: New production methods and applications
- A comprehensive review of nanofluids with fractional derivatives: Modeling and application
- Electrospinning of marine polysaccharides: Processing and chemical aspects, challenges, and future prospects
- Electrohydrodynamic printing for demanding devices: A review of processing and applications
- Rapid Communications
- Structural material with designed thermal twist for a simple actuation
- Recent advances in photothermal materials for solar-driven crude oil adsorption
Articles in the same Issue
- Research Articles
- Theoretical and experimental investigation of MWCNT dispersion effect on the elastic modulus of flexible PDMS/MWCNT nanocomposites
- Mechanical, morphological, and fracture-deformation behavior of MWCNTs-reinforced (Al–Cu–Mg–T351) alloy cast nanocomposites fabricated by optimized mechanical milling and powder metallurgy techniques
- Flammability and physical stability of sugar palm crystalline nanocellulose reinforced thermoplastic sugar palm starch/poly(lactic acid) blend bionanocomposites
- Glutathione-loaded non-ionic surfactant niosomes: A new approach to improve oral bioavailability and hepatoprotective efficacy of glutathione
- Relationship between mechano-bactericidal activity and nanoblades density on chemically strengthened glass
- In situ regulation of microstructure and microwave-absorbing properties of FeSiAl through HNO3 oxidation
- Research on a mechanical model of magnetorheological fluid different diameter particles
- Nanomechanical and dynamic mechanical properties of rubber–wood–plastic composites
- Investigative properties of CeO2 doped with niobium: A combined characterization and DFT studies
- Miniaturized peptidomimetics and nano-vesiculation in endothelin types through probable nano-disk formation and structure property relationships of endothelins’ fragments
- N/S co-doped CoSe/C nanocubes as anode materials for Li-ion batteries
- Synergistic effects of halloysite nanotubes with metal and phosphorus additives on the optimal design of eco-friendly sandwich panels with maximum flame resistance and minimum weight
- Octreotide-conjugated silver nanoparticles for active targeting of somatostatin receptors and their application in a nebulized rat model
- Controllable morphology of Bi2S3 nanostructures formed via hydrothermal vulcanization of Bi2O3 thin-film layer and their photoelectrocatalytic performances
- Development of (−)-epigallocatechin-3-gallate-loaded folate receptor-targeted nanoparticles for prostate cancer treatment
- Enhancement of the mechanical properties of HDPE mineral nanocomposites by filler particles modulation of the matrix plastic/elastic behavior
- Effect of plasticizers on the properties of sugar palm nanocellulose/cinnamon essential oil reinforced starch bionanocomposite films
- Optimization of nano coating to reduce the thermal deformation of ball screws
- Preparation of efficient piezoelectric PVDF–HFP/Ni composite films by high electric field poling
- MHD dissipative Casson nanofluid liquid film flow due to an unsteady stretching sheet with radiation influence and slip velocity phenomenon
- Effects of nano-SiO2 modification on rubberised mortar and concrete with recycled coarse aggregates
- Mechanical and microscopic properties of fiber-reinforced coal gangue-based geopolymer concrete
- Effect of morphology and size on the thermodynamic stability of cerium oxide nanoparticles: Experiment and molecular dynamics calculation
- Mechanical performance of a CFRP composite reinforced via gelatin-CNTs: A study on fiber interfacial enhancement and matrix enhancement
- A practical review over surface modification, nanopatterns, emerging materials, drug delivery systems, and their biophysiochemical properties for dental implants: Recent progresses and advances
- HTR: An ultra-high speed algorithm for cage recognition of clathrate hydrates
- Effects of microalloying elements added by in situ synthesis on the microstructure of WCu composites
- A highly sensitive nanobiosensor based on aptamer-conjugated graphene-decorated rhodium nanoparticles for detection of HER2-positive circulating tumor cells
- Progressive collapse performance of shear strengthened RC frames by nano CFRP
- Core–shell heterostructured composites of carbon nanotubes and imine-linked hyperbranched polymers as metal-free Li-ion anodes
- A Galerkin strategy for tri-hybridized mixture in ethylene glycol comprising variable diffusion and thermal conductivity using non-Fourier’s theory
- Simple models for tensile modulus of shape memory polymer nanocomposites at ambient temperature
- Preparation and morphological studies of tin sulfide nanoparticles and use as efficient photocatalysts for the degradation of rhodamine B and phenol
- Polyethyleneimine-impregnated activated carbon nanofiber composited graphene-derived rice husk char for efficient post-combustion CO2 capture
- Electrospun nanofibers of Co3O4 nanocrystals encapsulated in cyclized-polyacrylonitrile for lithium storage
- Pitting corrosion induced on high-strength high carbon steel wire in high alkaline deaerated chloride electrolyte
- Formulation of polymeric nanoparticles loaded sorafenib; evaluation of cytotoxicity, molecular evaluation, and gene expression studies in lung and breast cancer cell lines
- Engineered nanocomposites in asphalt binders
- Influence of loading voltage, domain ratio, and additional load on the actuation of dielectric elastomer
- Thermally induced hex-graphene transitions in 2D carbon crystals
- The surface modification effect on the interfacial properties of glass fiber-reinforced epoxy: A molecular dynamics study
- Molecular dynamics study of deformation mechanism of interfacial microzone of Cu/Al2Cu/Al composites under tension
- Nanocolloid simulators of luminescent solar concentrator photovoltaic windows
- Compressive strength and anti-chloride ion penetration assessment of geopolymer mortar merging PVA fiber and nano-SiO2 using RBF–BP composite neural network
- Effect of 3-mercapto-1-propane sulfonate sulfonic acid and polyvinylpyrrolidone on the growth of cobalt pillar by electrodeposition
- Dynamics of convective slippery constraints on hybrid radiative Sutterby nanofluid flow by Galerkin finite element simulation
- Preparation of vanadium by the magnesiothermic self-propagating reduction and process control
- Microstructure-dependent photoelectrocatalytic activity of heterogeneous ZnO–ZnS nanosheets
- Cytotoxic and pro-inflammatory effects of molybdenum and tungsten disulphide on human bronchial cells
- Improving recycled aggregate concrete by compression casting and nano-silica
- Chemically reactive Maxwell nanoliquid flow by a stretching surface in the frames of Newtonian heating, nonlinear convection and radiative flux: Nanopolymer flow processing simulation
- Nonlinear dynamic and crack behaviors of carbon nanotubes-reinforced composites with various geometries
- Biosynthesis of copper oxide nanoparticles and its therapeutic efficacy against colon cancer
- Synthesis and characterization of smart stimuli-responsive herbal drug-encapsulated nanoniosome particles for efficient treatment of breast cancer
- Homotopic simulation for heat transport phenomenon of the Burgers nanofluids flow over a stretching cylinder with thermal convective and zero mass flux conditions
- Incorporation of copper and strontium ions in TiO2 nanotubes via dopamine to enhance hemocompatibility and cytocompatibility
- Mechanical, thermal, and barrier properties of starch films incorporated with chitosan nanoparticles
- Mechanical properties and microstructure of nano-strengthened recycled aggregate concrete
- Glucose-responsive nanogels efficiently maintain the stability and activity of therapeutic enzymes
- Tunning matrix rheology and mechanical performance of ultra-high performance concrete using cellulose nanofibers
- Flexible MXene/copper/cellulose nanofiber heat spreader films with enhanced thermal conductivity
- Promoted charge separation and specific surface area via interlacing of N-doped titanium dioxide nanotubes on carbon nitride nanosheets for photocatalytic degradation of Rhodamine B
- Elucidating the role of silicon dioxide and titanium dioxide nanoparticles in mitigating the disease of the eggplant caused by Phomopsis vexans, Ralstonia solanacearum, and root-knot nematode Meloidogyne incognita
- An implication of magnetic dipole in Carreau Yasuda liquid influenced by engine oil using ternary hybrid nanomaterial
- Robust synthesis of a composite phase of copper vanadium oxide with enhanced performance for durable aqueous Zn-ion batteries
- Tunning self-assembled phases of bovine serum albumin via hydrothermal process to synthesize novel functional hydrogel for skin protection against UVB
- A comparative experimental study on damping properties of epoxy nanocomposite beams reinforced with carbon nanotubes and graphene nanoplatelets
- Lightweight and hydrophobic Ni/GO/PVA composite aerogels for ultrahigh performance electromagnetic interference shielding
- Research on the auxetic behavior and mechanical properties of periodically rotating graphene nanostructures
- Repairing performances of novel cement mortar modified with graphene oxide and polyacrylate polymer
- Closed-loop recycling and fabrication of hydrophilic CNT films with high performance
- Design of thin-film configuration of SnO2–Ag2O composites for NO2 gas-sensing applications
- Study on stress distribution of SiC/Al composites based on microstructure models with microns and nanoparticles
- PVDF green nanofibers as potential carriers for improving self-healing and mechanical properties of carbon fiber/epoxy prepregs
- Osteogenesis capability of three-dimensionally printed poly(lactic acid)-halloysite nanotube scaffolds containing strontium ranelate
- Silver nanoparticles induce mitochondria-dependent apoptosis and late non-canonical autophagy in HT-29 colon cancer cells
- Preparation and bonding mechanisms of polymer/metal hybrid composite by nano molding technology
- Damage self-sensing and strain monitoring of glass-reinforced epoxy composite impregnated with graphene nanoplatelet and multiwalled carbon nanotubes
- Thermal analysis characterisation of solar-powered ship using Oldroyd hybrid nanofluids in parabolic trough solar collector: An optimal thermal application
- Pyrene-functionalized halloysite nanotubes for simultaneously detecting and separating Hg(ii) in aqueous media: A comprehensive comparison on interparticle and intraparticle excimers
- Fabrication of self-assembly CNT flexible film and its piezoresistive sensing behaviors
- Thermal valuation and entropy inspection of second-grade nanoscale fluid flow over a stretching surface by applying Koo–Kleinstreuer–Li relation
- Mechanical properties and microstructure of nano-SiO2 and basalt-fiber-reinforced recycled aggregate concrete
- Characterization and tribology performance of polyaniline-coated nanodiamond lubricant additives
- Combined impact of Marangoni convection and thermophoretic particle deposition on chemically reactive transport of nanofluid flow over a stretching surface
- Spark plasma extrusion of binder free hydroxyapatite powder
- An investigation on thermo-mechanical performance of graphene-oxide-reinforced shape memory polymer
- Effect of nanoadditives on the novel leather fiber/recycled poly(ethylene-vinyl-acetate) polymer composites for multifunctional applications: Fabrication, characterizations, and multiobjective optimization using central composite design
- Design selection for a hemispherical dimple core sandwich panel using hybrid multi-criteria decision-making methods
- Improving tensile strength and impact toughness of plasticized poly(lactic acid) biocomposites by incorporating nanofibrillated cellulose
- Green synthesis of spinel copper ferrite (CuFe2O4) nanoparticles and their toxicity
- The effect of TaC and NbC hybrid and mono-nanoparticles on AA2024 nanocomposites: Microstructure, strengthening, and artificial aging
- Excited-state geometry relaxation of pyrene-modified cellulose nanocrystals under UV-light excitation for detecting Fe3+
- Effect of CNTs and MEA on the creep of face-slab concrete at an early age
- Effect of deformation conditions on compression phase transformation of AZ31
- Application of MXene as a new generation of highly conductive coating materials for electromembrane-surrounded solid-phase microextraction
- A comparative study of the elasto-plastic properties for ceramic nanocomposites filled by graphene or graphene oxide nanoplates
- Encapsulation strategies for improving the biological behavior of CdS@ZIF-8 nanocomposites
- Biosynthesis of ZnO NPs from pumpkin seeds’ extract and elucidation of its anticancer potential against breast cancer
- Preliminary trials of the gold nanoparticles conjugated chrysin: An assessment of anti-oxidant, anti-microbial, and in vitro cytotoxic activities of a nanoformulated flavonoid
- Effect of micron-scale pores increased by nano-SiO2 sol modification on the strength of cement mortar
- Fractional simulations for thermal flow of hybrid nanofluid with aluminum oxide and titanium oxide nanoparticles with water and blood base fluids
- The effect of graphene nano-powder on the viscosity of water: An experimental study and artificial neural network modeling
- Development of a novel heat- and shear-resistant nano-silica gelling agent
- Characterization, biocompatibility and in vivo of nominal MnO2-containing wollastonite glass-ceramic
- Entropy production simulation of second-grade magnetic nanomaterials flowing across an expanding surface with viscidness dissipative flux
- Enhancement in structural, morphological, and optical properties of copper oxide for optoelectronic device applications
- Aptamer-functionalized chitosan-coated gold nanoparticle complex as a suitable targeted drug carrier for improved breast cancer treatment
- Performance and overall evaluation of nano-alumina-modified asphalt mixture
- Analysis of pure nanofluid (GO/engine oil) and hybrid nanofluid (GO–Fe3O4/engine oil): Novel thermal and magnetic features
- Synthesis of Ag@AgCl modified anatase/rutile/brookite mixed phase TiO2 and their photocatalytic property
- Mechanisms and influential variables on the abrasion resistance hydraulic concrete
- Synergistic reinforcement mechanism of basalt fiber/cellulose nanocrystals/polypropylene composites
- Achieving excellent oxidation resistance and mechanical properties of TiB2–B4C/carbon aerogel composites by quick-gelation and mechanical mixing
- Microwave-assisted sol–gel template-free synthesis and characterization of silica nanoparticles obtained from South African coal fly ash
- Pulsed laser-assisted synthesis of nano nickel(ii) oxide-anchored graphitic carbon nitride: Characterizations and their potential antibacterial/anti-biofilm applications
- Effects of nano-ZrSi2 on thermal stability of phenolic resin and thermal reusability of quartz–phenolic composites
- Benzaldehyde derivatives on tin electroplating as corrosion resistance for fabricating copper circuit
- Mechanical and heat transfer properties of 4D-printed shape memory graphene oxide/epoxy acrylate composites
- Coupling the vanadium-induced amorphous/crystalline NiFe2O4 with phosphide heterojunction toward active oxygen evolution reaction catalysts
- Graphene-oxide-reinforced cement composites mechanical and microstructural characteristics at elevated temperatures
- Gray correlation analysis of factors influencing compressive strength and durability of nano-SiO2 and PVA fiber reinforced geopolymer mortar
- Preparation of layered gradient Cu–Cr–Ti alloy with excellent mechanical properties, thermal stability, and electrical conductivity
- Recovery of Cr from chrome-containing leather wastes to develop aluminum-based composite material along with Al2O3 ceramic particles: An ingenious approach
- Mechanisms of the improved stiffness of flexible polymers under impact loading
- Anticancer potential of gold nanoparticles (AuNPs) using a battery of in vitro tests
- Review Articles
- Proposed approaches for coronaviruses elimination from wastewater: Membrane techniques and nanotechnology solutions
- Application of Pickering emulsion in oil drilling and production
- The contribution of microfluidics to the fight against tuberculosis
- Graphene-based biosensors for disease theranostics: Development, applications, and recent advancements
- Synthesis and encapsulation of iron oxide nanorods for application in magnetic hyperthermia and photothermal therapy
- Contemporary nano-architectured drugs and leads for ανβ3 integrin-based chemotherapy: Rationale and retrospect
- State-of-the-art review of fabrication, application, and mechanical properties of functionally graded porous nanocomposite materials
- Insights on magnetic spinel ferrites for targeted drug delivery and hyperthermia applications
- A review on heterogeneous oxidation of acetaminophen based on micro and nanoparticles catalyzed by different activators
- Early diagnosis of lung cancer using magnetic nanoparticles-integrated systems
- Advances in ZnO: Manipulation of defects for enhancing their technological potentials
- Efficacious nanomedicine track toward combating COVID-19
- A review of the design, processes, and properties of Mg-based composites
- Green synthesis of nanoparticles for varied applications: Green renewable resources and energy-efficient synthetic routes
- Two-dimensional nanomaterial-based polymer composites: Fundamentals and applications
- Recent progress and challenges in plasmonic nanomaterials
- Apoptotic cell-derived micro/nanosized extracellular vesicles in tissue regeneration
- Electronic noses based on metal oxide nanowires: A review
- Framework materials for supercapacitors
- An overview on the reproductive toxicity of graphene derivatives: Highlighting the importance
- Antibacterial nanomaterials: Upcoming hope to overcome antibiotic resistance crisis
- Research progress of carbon materials in the field of three-dimensional printing polymer nanocomposites
- A review of atomic layer deposition modelling and simulation methodologies: Density functional theory and molecular dynamics
- Recent advances in the preparation of PVDF-based piezoelectric materials
- Recent developments in tensile properties of friction welding of carbon fiber-reinforced composite: A review
- Comprehensive review of the properties of fly ash-based geopolymer with additive of nano-SiO2
- Perspectives in biopolymer/graphene-based composite application: Advances, challenges, and recommendations
- Graphene-based nanocomposite using new modeling molecular dynamic simulations for proposed neutralizing mechanism and real-time sensing of COVID-19
- Nanotechnology application on bamboo materials: A review
- Recent developments and future perspectives of biorenewable nanocomposites for advanced applications
- Nanostructured lipid carrier system: A compendium of their formulation development approaches, optimization strategies by quality by design, and recent applications in drug delivery
- 3D printing customized design of human bone tissue implant and its application
- Design, preparation, and functionalization of nanobiomaterials for enhanced efficacy in current and future biomedical applications
- A brief review of nanoparticles-doped PEDOT:PSS nanocomposite for OLED and OPV
- Nanotechnology interventions as a putative tool for the treatment of dental afflictions
- Recent advancements in metal–organic frameworks integrating quantum dots (QDs@MOF) and their potential applications
- A focused review of short electrospun nanofiber preparation techniques for composite reinforcement
- Microstructural characteristics and nano-modification of interfacial transition zone in concrete: A review
- Latest developments in the upconversion nanotechnology for the rapid detection of food safety: A review
- Strategic applications of nano-fertilizers for sustainable agriculture: Benefits and bottlenecks
- Molecular dynamics application of cocrystal energetic materials: A review
- Synthesis and application of nanometer hydroxyapatite in biomedicine
- Cutting-edge development in waste-recycled nanomaterials for energy storage and conversion applications
- Biological applications of ternary quantum dots: A review
- Nanotherapeutics for hydrogen sulfide-involved treatment: An emerging approach for cancer therapy
- Application of antibacterial nanoparticles in orthodontic materials
- Effect of natural-based biological hydrogels combined with growth factors on skin wound healing
- Nanozymes – A route to overcome microbial resistance: A viewpoint
- Recent developments and applications of smart nanoparticles in biomedicine
- Contemporary review on carbon nanotube (CNT) composites and their impact on multifarious applications
- Interfacial interactions and reinforcing mechanisms of cellulose and chitin nanomaterials and starch derivatives for cement and concrete strength and durability enhancement: A review
- Diamond-like carbon films for tribological modification of rubber
- Layered double hydroxides (LDHs) modified cement-based materials: A systematic review
- Recent research progress and advanced applications of silica/polymer nanocomposites
- Modeling of supramolecular biopolymers: Leading the in silico revolution of tissue engineering and nanomedicine
- Recent advances in perovskites-based optoelectronics
- Biogenic synthesis of palladium nanoparticles: New production methods and applications
- A comprehensive review of nanofluids with fractional derivatives: Modeling and application
- Electrospinning of marine polysaccharides: Processing and chemical aspects, challenges, and future prospects
- Electrohydrodynamic printing for demanding devices: A review of processing and applications
- Rapid Communications
- Structural material with designed thermal twist for a simple actuation
- Recent advances in photothermal materials for solar-driven crude oil adsorption